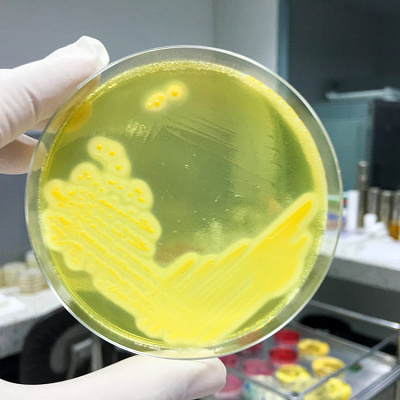

Лимфаденит у детей
Лимфаденит у детей — это острое либо хроническое воспалительное заболевание лимфатических узлов, которое развивается на фоне инфекционного воспалительного процесса. Становление патологического состояния происходит в результате фильтрации инфекционных агентов (для чего и предназначены лимфатические узлы как составная часть иммунной системы человека). Развитие лимфаденита непредсказуемо и обычно происходит после перенесенного инфекционного заболевания или на фоне длительного течения того или иного септического расстройства.
Диагностика и лечение патологического процесса проводятся обязательно. Терапия, как и обследование, может быть работой разных специалистов: отоларинголога, педиатра, прочих. В зависимости от первичной причины нарушения. Коррекция консервативная или же оперативная, по ситуации.

Причины развития лимфаденита у детей
Воспаление лимфатических узлов у детей всегда имеет инфекционную природу. Патологический процесс развивается на фоне поражения бактериальными агентами. Реже в развитии нарушения участвуют грибки, вирусные агенты. Оценка патологического состояния проводится инструментальными и лабораторными методами. С пациентами младшей возрастной группы работают врачи-педиатры, отоларингологи и прочие, в зависимости от вероятной природы расстройства.
Патогенез заболевания
В основе патогенеза заболевания, увеличения и воспаления лимфоузлов, лежат инфекции. Другой генез патологического процесса у детей практически не встречается. Воспалительный процесс развивается в результате влияния большой группы агентов, среди которых:
- стрептококки, представители гноеродной, пиогенной флоры, которые отличаются высокой агрессивностью;
- стафилококки, не менее агрессивные и так же широко распространены (как стрептококки);
- представители специфической флоры: хламидии, бледные спирохеты, а также микоплазмы.
Лимфаденит у ребенка развивается и в результате заражения микобактериями туберкулеза. Но это более редкий случай. В большинстве своем микроорганизмы представлены стафилококковой и стрептококковой флорой (неспецифический лимфаденит у ребенка).
Есть группа патологий, которые провоцируют развитие лимфаденита. Наиболее часто расстройство развивается в результате течения:
- синусита, воспалительного процесса со стороны придаточных пазух носа (обычно гайморовых, но возможны и другие варианты);
- тонзиллита, воспалительного поражения горла, небных миндалин (по другому это состояние называется ангиной);
- большую роль играют очаги поражения органов слуха, отиты, воспаления наружного, среднего и внутреннего уха;
- стоматитов, воспалительных заболеваний слизистой оболочки ротовой полости;
- пиодермий, то есть гнойных поражений кожного покрова (кожа может поражаться возбудителями гноеродного ряда);
- ОРВИ, острые респираторные вирусные инфекции играют свою роль, это собирательное название группы патогенов, которые провоцируют поражения верхних дыхательных путей.
Часто лимфатическая система подвергается нагрузкам из-за стоматологических заболеваний. В частности, опасен глубокий кариес (пульпит), возможно воспаление на фоне периодонтита (встречается не так часто, но такое тоже возможно). Болезнь в этом случае в большинстве своем хроническая, является серьезной медицинской проблемой. Требует санации инфекционного очага.
Возможные факторы риска
Факторы риска не вызывают непосредственного развития патологического процесса. Но они играют свою негативную роль в формировании расстройства, если имеется непосредственная причина заболевания. Воспалительная реакция организма более вероятна, если есть по меньшей мере один из следующих факторов:
- частые ОРВИ, особенно в раннем возрасте, поскольку иммунная система постепенно истощается, требуется больше усилий по блокировке инфекционных агентов;
- стоматологические заболевания, независимо от формы, увеличивают вероятность патологического процесса на уровне шеи (шейный лимфаденит);
- заболевания ЛОР-профиля, поражения уха, горла, носа любого характера, вероятность лимфаденита обычно существенно выше, если имеет место хроническое поражение;
- воспалительные процессы со стороны тканей организма, независимо от того, где и как они протекают, развитие лимфаденита возможно при любом воспалительном процессе;
- хронические поражения, заболевания любой локализации, поскольку они подтачивают защитные силы организма;
- общее снижение интенсивности работы иммунной системы человека.
Причины, факторы риска в детском возрасте и у взрослых требуют обязательной квалифицированной оценки. С пациентами работают врачи-педиатры и специалисты по профилю, в зависимости от основного диагноза. Проводится специальное обследование.
Классификация и формы патологического процесса
Есть несколько способов классификации диагноза лимфаденита. Первый способ основывается на происхождении патологического процесса. Выделяют первичные и вторичные формы расстройства. Первичные у детей почти не встречаются. При вторичных лимфатические узлы воспаляются как результат течение того или иного заболевания (среди тех, что описаны ранее и не только). По-другому вторичное расстройство называется реактивным лимфаденитом у ребенка.
Второе основание классификации — возбудитель, который спровоцировал расстройство. Наиболее частый вариант — несецифический лимфаденит у ребенка. Он развивается в результате влияния стафилококков и стрептококков. То есть флоры, которая называется неспецифической (универсальна в своем роде и поражает любые системы организма). Специфическое поражение возникает при инфицировании спирохетами, хламидиями и прочими агентами венерического ряда. У детей такое встречается редко.
Третье основание классификации — характер течения патологического процесса. Соответственно, называют:
- острый лимфаденит у детей, который существует до 2 недель и быстро сходит на нет (особенно при правильном лечении);
- подострую форму, болезнь характеризуется более длительным течением, продолжается до месяца;
- хроническое поражение, наблюдается длительное течение, более месяца, возможны периоды некоторого облегчения, за которыми следуют обострения.
Острые формы обычно протекают с гнойными осложнениями. Особенно, если человек не получает достаточного лечения. Гнойный лимфаденит у детей сопровождается потенциально смертоносными последствиями. Требуется немедленная помощь врача. Терапия проводится в условиях стационара.
Деление патологического процесса возможно по локализации расстройства, встречаются:
- шейный лимфаденит у детей, развивается в результате поражения шейной области;
- подчелюстная форма лимфаденита у детей, которая развивается при поражении подчелюстной, лицевой области пациента;
- околоушный или заушный лимфаденит (лимфаденит за ухом у ребенка чаще всего развивается при поражении органов слуха);
- затылочный лимфаденит у ребенка;
- подмышечный лимфаденит у детей (местные проявления в подмышечной области развиваются в результате самых разных воспалений, независимо от локализации основного очага);
- брыжеечный лимфаденит у детей он же мезентериальный лимфаденит у детей, который развивается как осложнение воспалительных процессов со стороны органов брюшной полости (мезентериальный лимфаденит потенциально опасен из-за рисков распространения воспалительного процесса);
- лимфаденит в паху у ребенка, поражение паха, паховой зоны встречается при воспалении органов репродуктивной системы, почек и не только.
Возможно развитие сразу нескольких видов лимфатического поражения. Иногда инфекция попадает в разные узлы. Так развиваются заушный лимфаденит у ребенка вместе с подчелюстной формой. Или околоушной лимфаденит у детей в системе с поражением узлов в области шеи.
Наконец, деление патологического состояния на группы возможно по характеру изменений в лимфоузле. Выделяются:
- серозный тип: сопровождается инфильтрационными изменениями, на месте поражения развивается болезненное уплотнение;
- гнойный тип, сопровождается гнойным воспалением лимфатического узла и куда более явными, характерными симптомами патологического процесса;
- некротическое поражение с расплавом лимфоузла;
- аденофлегмона, ее появление возможно при длительном течении гнойной формы без достаточной терапии (неспецифические возбудители такой исход провоцируют редко, только при существенном ослаблении иммунитета пациента).
Все методы классификации используются для более точного, подробного описания патологического процесса. Задача решается под контролем врача. Подробная классификация позволяет быстрее назначить грамотную терапию.
Симптомы лимфаденита у детей
Симптомы лимфаденита у детей зависят от характера патологического процесса. Обычно присутствуют такие признаки:
- резкая болезненность в области поражения и поблизости (боли стихают, а затем вновь усиливаются);
- локальный лимфостаз, лимфаденопатия (собственно воспаление) провоцирует нарушение нормального оттока лимфы, из-за чего развиваются сильные отеки тканей на местном уровне;
- образование болезненного уплотнения, которое нередко возвышается над кожей (размер может достигать нескольких см);
- при остром, тяжелом воспалении наблюдается локальная гиперемия, покраснение области поражения, кожи над местом воспалительного процесса;
- общее нарушение самочувствия, лихорадка, слабость, повышение температуры тела.
Возможны различные нарушения со стороны внутренних органов (со стороны органов брюшной полости и т. д.). В таком случае развиваются иные локальные признаки: боли в животе, расстройства стула и прочие.
Признаки лимфаденита у детей очень различны. При относительно легком течении патологического процесса проявлений может не быть вообще. Все зависит от клинического случая и индивидуальных особенностей, параметров организма пациента.
Осложнения патологического процесса
Осложнения патологии происходят, если пациент не получает достаточной терапии. Обычно наблюдается хронизация патологического процесса, но возможны и более опасные нарушения.
Наиболее часто развиваются патологические состояния, которые несут опасность уже в краткосрочной перспективе. При хроническом поражении лимфатические узлы увеличиваются на постоянной основе. Болезнь стихает, а затем снова обостряется и так по кругу, что само по себе несет риск иных осложнений. Возможно ухудшение функционирования тех или иных органов пациента. В первые годы жизни часто развиваются гнойный осложнения, вплоть до расплава лимфоузла, развития флегмоны, даже сепсиса, генерализованного воспалительного процесса (называется заражением крови). Поражения затылочной области, шеи и области лица чреваты воспалением местных сосудов, тромбозами, поражениями головного мозга пациента. Брыжеечные, связанные с поражением органов ЖКТ формы, чреваты гангреной кишечника. По нашим оценкам, осложнения появляются без достаточной терапии (начинаться она должна в течение первых 2-3 дней от манифестации патологического процесса). Далее вероятность осложнений только растет.

Один из главных способов профилактики осложнений — своевременной лечение патологического процесса.
Диагностика заболевания
Диагностика патологического процесса при неизвестном происхождении расстройства — работа педиатра. Обследование начинается с осмотра. Устанавливается факт воспаления лимфоузла. Для диагностики применяется серия первичных методик: опрос пациента или его родителей, сбор анамнеза, а также пальпация пораженной области (пальпировать нужно осторожно, во избежание осложнений). Далее наступает очередь специфических тестов:
- УЗИ: делают для определения состояния лимфатического узла, непосредственной визуализации тканей;
- рентгенографии, если заболевание предположительно связано с тем или иным поражением внутренних органов;
- анализов крови, общего и биохимического;
- туберкулиновой пробы, чтоб исключить туберкулезную форму патологического процесса;
- пункции, которая нередко становится необходимостью (проводится биопсия с изучением характера возбудителя воспалительного процесса).
В большей части случаев для выявления причин лимфаденита у детей проводятся серологические и бактериологические исследования.
По результатам клинические данные связывают с конкретным заболеванием. Назначают непосредственно само лечение.
Лечение лимфаденита у детей
Лечение лимфаденита у детей при легком и умеренном течении патологического процесса начинается с консервативной коррекции. Применяются антибиотики. Это универсальный путь коррекции. При остром лимфадените шеи у ребенка, паховом лимфадените у детей антибиотики — главный метод лечения патологического состояния.
Возможно проведение хирургической коррекции. Но оперативное лечение требуется при гнойном поражении, а также расплаве тканей. Важно санировать и очистить пораженный участок, провести качественную антисептическую обработку тканей. Лимфаденит на шее у ребенка требует более деликатного отношения из-за близости множества сосудов. Острый шейный лимфаденит у детей, гнойные формы расстройства требуют госпитализации и стационарного лечения. При оперативной коррекции возможно удаление лимфоузла.
Реактивные формы дополнительно предполагают выявление причины патологического процесса. Устранение факторов-провокаторов расстройства.
Прогнозы патологического процесса
При своевременном лечении расстройства прогнозы благоприятные. Наступает полное выздоровление. В противном случае перспективы туманные, прогнозы индивидуальные и всегда серьезные.
Методы профилактики патологии
Профилактика патологического процесса включает своевременное лечение ОРВИ, устранение источников хронической инфекции. Важно придерживаться адекватных правил гигиены, а также избегать контактов с источниками инфекционного поражения.
Источники
- Робустова Т. Г. Хирургическая стоматология. — 4-е изд., перераб. и доп. — М.: Медицина, 2010.
- Козарезова Т. И. и др. Синдром лимфаденопатии у детей. — М.: БГМУ, 2006.
- Диагностика лимфаденопатий. Клинические рекомендации РФ 2018-2020 (Россия).
- Лимфадениты, лимфангоиты, лимфаденопатии челюстно-лицевой области : учеб.-метод. пособие / Н. Н. Черченко [и др.]. – Минск: БГМУ, 2007 – 19 с.
- Дворецкий Л. И. Лимфаденопатия: от синдрома к диагнозу. РМЖ. №4. 2014 г. 310–314 с.
- Демко И.В., Собко Е.А., Гордеева Н.В., Крапошина А.Ю., Мамаева М.Г., Шестакова Н.А., Кацер А.Б. Медиастинальная лимфаденопатия: трудности дифференциальной диагностики. Профилактическая медицина. 2023;26(1):89‑94.

Ответы на вопросы
Может ли лимфаденит развиться у полностью здорового ребенка?
Да, такое возможно. Но на фоне мнимого благополучия (на самом деле ребенок не здоровый). В большинстве случаев источник инфекции все-таки есть. Однако патологическое состояние развивается внезапно, что становится сюрпризом. Вопрос не в отсутствии источника проблемы, а в недостаточном внимании к здоровью ребенка.
Проходит ли заболевание само?
Заболевание может затихнуть. Но полного восстановления без достаточной терапии патологического процесса ждать не стоит. Требуется профессиональная, квалифицированная медицинская помощь.
Обязательна ли операция?
Лечение лимфаденита, симптомов у детей требует консервативного и хирургического подхода. Но операция выступает крайней мерой. В большинстве случаев патологический процесс удается взять под контроль без операции. Последнее слово остается за специалистом.
Сколько времени длится болезнь?
Лечение патологического процесса занимает от 2 до 4 недель (в среднем). Иногда требуется чуть больше времени. При операции дополнительное время нужно закладывать на восстановление, реабилитационный период, который продолжается еще 1-2 месяца.
К каким врачам обращаться?
Первым же делом рекомендуется обратиться к врачу-педиатру. Остальные специалисты (отоларинголог, фтизиатр, хирург, а также инфекционист) участвуют в диагностике и лечении от случая к случаю. В зависимости от клинической ситуации.
Заболевания по направлению Детский ЛОР
Лицензии

Мы осуществляем деятельность на основании медицинских лицензий в соответствии с рекомендациями Минздрава